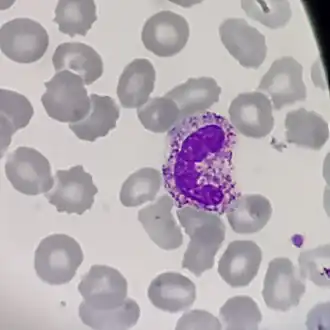

Staafkernige neutrofiele granulocyt
Staven (ook wel staafkernigen of staafkernige neutrofiele granulocyten) zijn cellen die granulopoese ondergaan, ontstaan uit metamyelocyten, en leidend tot rijpe granulocyten.
Deze cellen worden gekarakteriseerd door staafvormige kernen, in tegenstelling tot segmentkernige kernen.
Meestal wordt met "staven" neutrofiele granulocyten aangeduid, maar de term "staaf" wordt ook toegepast binnen andere cellijnen, zoals basofielen.
Een verhoogd aantal staven is een teken van infectie. Een relatief groot aantal (jonge) staven ten opzichte van (rijpe) segmentkernigen wordt ook wel een linksverschuiving genoemd.
Zie de categorie Band cells van Wikimedia Commons voor mediabestanden over dit onderwerp.